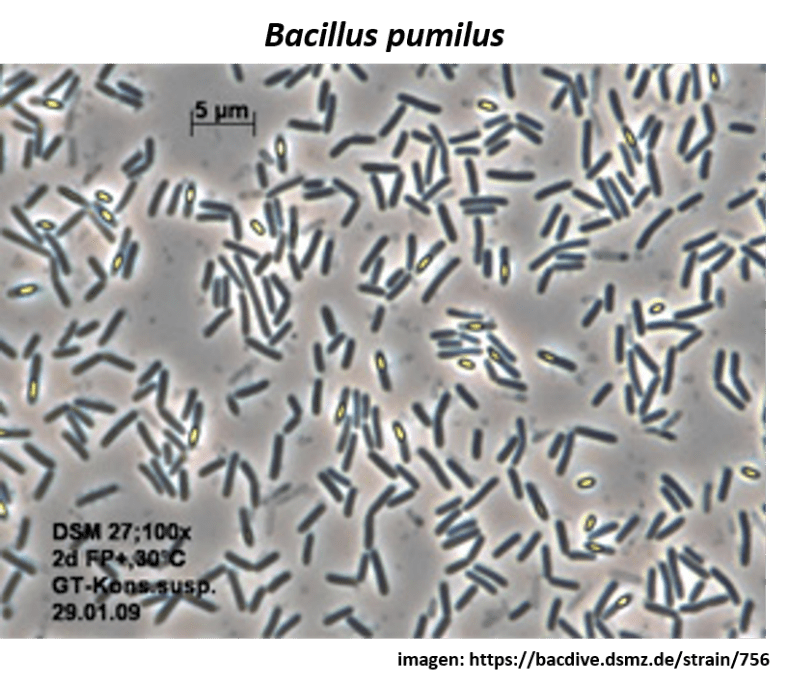

La mejor forma de estabilizar el Fósforo y reducir su bloqueo implica la inclusión de un 5% de un ácido húmico soluble con los fertilizantes granulados de dicho elemento, es decir, 5.0 kg por cada 100 kg. El ácido húmico soluble se disuelve a la misma velocidad que el DAP/ MAP, y se forma un humato de fosfato estable. Así, se tendrá fosfato disponible para toda la temporada, en vez de solo las primeras 6 semanas (6).
Las aportaciones de Fosfato ácido son muy agresivas con los hongos micorrícicos del suelo, sin embargo, el ácido húmico amortigua la quemadura y al mismo tiempo estimula a todos los hongos benéficos, incluidos las Micorrizas Arbusculares (AMF). El ácido húmico también promueve el crecimiento de las raíces y mejora la estructura del suelo.
Asimismo, induce un fenómeno que ha sido bien investigado llamado «sensibilización celular», en el que la membrana celular se vuelve más permeable y es capaz de absorber entre un 30 % y un 34 % más de Fosforo. De ahí que la inclusión de un 5.0 % de ácido húmico puede resultar gratuita a la luz de este descubrimiento.
Debido a esta mejora de 1/3 en la absorción de Fósforo, existe la posibilidad de reducir la cantidad de fertilizantes de Fosforo en unos pocos kilos y así cubrir el costo de los humatos.
Otra manera de reducir las aportaciones de Fósforo implica diseñar estrategias para promover la liberación de su reserva bloqueada:
- Las leguminosas exudan ácidos que pueden liberar el Fósforo retenido. La inclusión de tréboles bajo de un cultivo de cereal puede proporcionar tanto Nitrógeno como Fósforo al cultivo huésped, y al mismo tiempo, suministrar algo de Calcio.
- El tratamiento de semillas con hongos micorrízicos (AMF) puede costar menos de $10 por hectárea. Estos organismos son famosos por su capacidad para accesar al fósforo del suelo. La extensión masiva de raíces de diminutos filamentos que promueven, permite un acceso mucho mayor al más inmóvil de todos los minerales. Este aumento del 1000 % en la zona de la superficie de la raíz permite extraer Fósforo que se encuentra a una distancia mucho mayor, al tiempo que se liberan ácidos para romper el enlace entre el fosfato y el calcio.
- El tratamiento de semillas con hongos micorrízicos (AMF) puede costar menos de $10 por hectárea. Estos organismos son famosos por su capacidad para accesar al fósforo del suelo. La extensión masiva de raíces de diminutos filamentos que promueven, permite un acceso mucho mayor al más inmóvil de todos los minerales. Este aumento del 1000 % en la zona de la superficie de la raíz permite extraer Fósforo que se encuentra a una distancia mucho mayor, al tiempo que se liberan ácidos para romper el enlace entre el fosfato y el calcio.
- El ácido fúlvico es un solubilizador de Fósforo bien investigado, por lo que puede incluirse en los programas de inyección de líquido en la siembra o al momento del establecimiento de la plantación para liberar algunas de las reservas de Fósforo.
- Una táctica más para el manejo del Fósforo es la exploración de fuentes alternativas, como puede ser el estiércol de pollo. En nuestra región todavía se puede obtener por $20 por metro, ya entregado. Si solamente ponemos atención en su contenido de Fósforo que es del 2%, esto equivale a 20 kg de fosfato puro, es decir, el equivalente a casi 100 kg de DAP. Este tipo de estiércol es 5 veces más barato que el DAP, por unidad de Fósforo, y también contiene buenos niveles de Nitrógeno, Potasio, Calcio y Azufre junto con minerales traza, Carbono y microorganismos. Esta ganga de $ 20 en realidad tiene un valor de más de $ 200.
- Finalmente, debemos considerar las bacterias promotoras del crecimiento vegetal (PGPB). Hay varias cepas de Bacillus súper productivas, todas ellas pueden solubilizar el fósforo inmovilizado: Bacillus megaterium es el gran especialista en esta función, pero Bacillus subtilis, Bacillus amyloliquefaciens, Bacillus pumilus y Bacillus licheniformis pueden accesar a sus reservas de Fosforo al mismo tiempo que ofrecen muchos otros beneficios. Cuatro de ellas también pueden fijar Nitrógeno y una de ellas solubiliza Potasio. Pueden controlar múltiples enfermedades, incluidas enfermedades de las plántulas como Pythium, y aumentan la inmunidad y el rendimiento mediante la producción de múltiples estimulantes del crecimiento vegetal.
Hay una nueva investigación confiable que sugiere que una combinación de Sílice, Micorrizas arbusculares (AMF) y Bacterias promotoras del crecimiento vegetal (PGPB) puede ser súper productiva en términos de un mayor suministro de Fosfato para la planta (7)
Fuente: “Chasing the Biggest Bang – Ten Tips to Reduce Input Costs”. Graeme Sait.
https://blog.nutri-tech.com.au/chasing-the-biggest-bang/